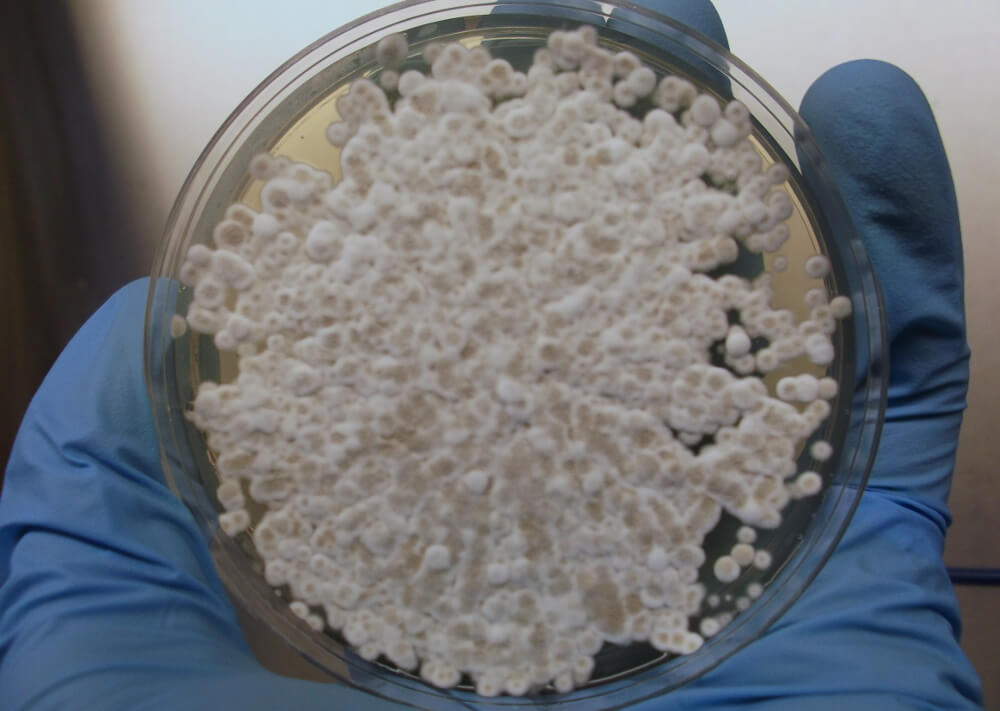
В США гибнут миллионы летучих мышей. Что их убивает? Как вылечить болезнь? Фото.

Уже 12 лет подряд в пещерах восточной части США лежат горы мертвых тел крошечных летучих мышей. Все они умирают из-за так называемого синдрома белого носа, вызываемого грибком, приводящим к разрушению крыльев, потере жира и, в конечном счете, к смерти. На данный момент количество погибших из-за болезни животных исчисляется миллионами, и жертв становится все больше — недавно зараженные особи были найдены даже в Калифорнии. Власти всерьез обеспокоены массовой гибелью летучих мышей, потому что без них жители США могут заразиться опасными болезнями и лишиться еды.

Считается, что грибок Pseudogymnoascus destructans изначально возник в Европе, а потом перебрался в Северную Америку. Он активно размножается при низких температурах, а летучие мыши как раз зимуют в холодных пещерах и во время спячки становятся уязвимыми к болезням. Пользуясь слабостью животных, грибок уже убил легионы 45 видов летучих мышей в 38 штатах Америки.
Как распространяется грибок?
В 2018 году биологи обнаружили зараженных мышей даже в Калифорнии. Всего они нашли только четыре особи с белыми носами, но они могут легко заразить сотни, и даже тысячи своих сородичей. Дело в том, что эти животные спят очень плотно друг к другу, поэтому для заражения целой стаи хватает даже одной заболевшей мыши. Также опасный грибок может тихо поджидать их на протяжении десяти лет даже в пустой пещере.

Зараженная летучая мышь
Как вылечить болезнь?
Также переносчиками болезни могут быть люди — грибок не опасен для нашего здоровья, но мы можем распространять его споры на одежде и обуви. В связи с этим, власти некоторых штатов Америки запрещают людям посещать пещеры. Также они предлагают пускать летучих мышей на зимовку внутрь военных бункеров с контролируемой температурой — так, по их мнению, животных можно хоть как-то защитить от заражения.
Грибок Pseudogymnoascus destructans
Также биологи пытались бороться с эпидемией при помощи химикатов, но в итоге было обнаружено, что они могут нанести летучим мышам еще больший вред. На данный момент лучшим способом защиты животных от болезни считается распыление вакцины, однако ее пока не существует — по расчетам биологов, на разработку может уйти несколько лет.
Что едят летучие мыши?
Ученые хотят остановить вымирание летучих мышей потому, что они крайне полезны для людей. Например, они активно истребляют комаров, распространяющих лихорадку Западного Нила — эта инфекция вызывает воспаления мозговых оболочек и может привести к смерти.
Советуем почитать: 10 вещей, которые пропадут навсегда, если исчезнут пчелы
Также летучие мыши уничтожают сельскохозяйственных вредителей, которые наносят ущерб урожаю хлопка и кукурузы. Помимо этого, они опыляют растение под названием агава, сердцевина которой используется для производства текилы. В целом, благодаря летающим созданиям, США ежегодно экономит 3,7 миллиардов долларов.
Действительно ли опасна болезнь?
Возможно, биологи рано наводят панику, потому что в теплой Калифорнии болезнь может распространяться гораздо медленнее, чем в холодных штатах. Однако, даже если она не будет распространяться в Калифорнии, ученым крайне важно разработать от нее вакцину, потому что с такими темпами летучие мыши вовсе могут превратиться в исчезающий вид животных.
Рекомендуем почитать: Почему летучие мыши хорошо переносят вирус Эбола и другие смертельные заболевания?
Если вам интересны новости науки и технологий, подпишитесь на наш канал в Яндекс.Дзен. Там вы найдете материалы, которые не были опубликованы на сайте!



Новости, статьи и анонсы публикаций
Чат с читателямиСвободное общение и обсуждение материалов